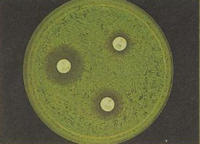

天然ひのき油・ヒバ油・ひば水:通販・販売のイーストエコ
和製アロマ等、天然・自然の良さをお買得価格にてお届けいたします
|
◆商品一覧◆
|
| ■木工品 |
| ・ヒノキまな板 |
| ・ヒノキチップ |
| ■天然防蟻剤 |
| ・キセイテックPRO水性剤 |
| ・キセイテックPRO2003 |
| ・キセイテックPROSOLN |
100ml以下の商品は全品送料無料!
|
天然ヒバ油の効果
|
◆抗菌効果
カビや細菌の発育を阻止する働きがあります。
MRSAに対するヒバ油の抗菌試験
O-157に対するヒバ油の抗菌試験
黄コウジカビに対するヒバ油の抗菌試験
天然ヒバ油にはカビや細菌など多くの菌に対する抗菌性があることがわかっています。
これは、ヒバ油に含まれるヒノキチオールなどの成分によるものです。
また、非常に多くの菌に対して抗菌性を発揮すること、その中でも特にカビや腐朽菌に対して効果が高いこと、耐性菌の出現が少ないことが特徴です。
最小発育阻止濃度黄色ブドウ球菌 連鎖球菌 大腸菌 緑膿菌 霊菌 枯草菌 サルモネラ菌
内容等の転載・転用は、部分的なものも含め禁止いたします。
その他の天然樹木油関連商品のご案内
 天然青森ひば精油 天然青森ひば精油お買得! 天然ヒノキチオール2%含有。 肌荒れ、体臭(加齢臭)気になる方へお買得価格 ヒバ油の効果 |
 天然ひのき油 天然ひのき油本物の桧の香りはいかがですか? 100%天然 アロマテラピー、 お部屋、木工品の香り付けにどうぞ! |
 天然ひば水 天然ひば水お買得! 肌荒れ、カサつき、お肌のトラブルに。 天然ヒノキチオールが活躍! ひばの香りです。 |
 ヒノキチップ ヒノキチップ国産の桧をカールチップに。桧のいい香りがします。枕に入れたり、桧精油とセットでお部屋の芳香にどうぞ! |
 ひば石けん類 ひば石けん類天然ヒバ油配合、天然ヒノキチオール含有 お肌がしっとり、さっぱり! |
 天然・無農薬シロアリ防除剤 天然・無農薬シロアリ防除剤ヒバ油・ヒノキチオールの防虫効果を利用した天然・無農薬の安心できる防蟻剤です! |
内容等の転載・転用は、部分的なものも含め禁止いたします。
Copyright (C) 2002-2010 Easteco. All Rights Reserved.
更新10/06/25